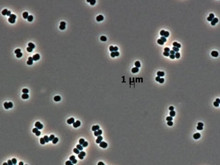
Ölü taklidi yapan süper bakteriler, uzayı bile tehdit ediyor

Sağlık
Sağlık
 Neden karanlıkta uyumalısınız? İşte yapay ışıkta uyuyanları bekleyen tehlikeler
Neden karanlıkta uyumalısınız? İşte yapay ışıkta uyuyanları bekleyen tehlikeler
Neden karanlıkta uyumalısınız? İşte yapay ışıkta uyuyanları bekleyen tehlikeler
Neden karanlıkta uyumalısınız? İşte yapay ışıkta uyuyanları bekleyen tehlikeler
 Sağlıkta yeni soru: Yapay zeka bir rakip mi, vazgeçilmez bir ortak mı?
Sağlıkta yeni soru: Yapay zeka bir rakip mi, vazgeçilmez bir ortak mı?
Sağlıkta yeni soru: Yapay zeka bir rakip mi, vazgeçilmez bir ortak mı?
Sağlıkta yeni soru: Yapay zeka bir rakip mi, vazgeçilmez bir ortak mı?